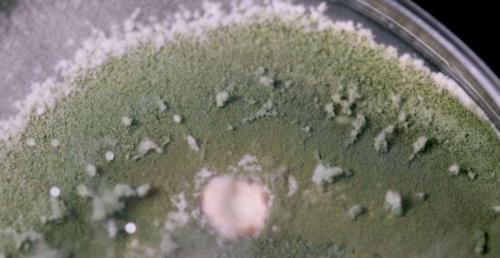

图书馆怎么画
时间:2019-11-06
本次我们画用书搭建起来的图书馆。首先用铅笔画出两本立起来的书。
然后继续画出一本书叠在上面,这样一个大概的框架就搭好了。
在中间的空间画出一排排整齐的书架,一本本精致的书籍,中间也画上书柜、看书的人物。
之后我们就可以开始填色了,先把外部的框架书籍填上喜欢的颜色。

原创 | 2023-04-15 12:49:47 |浏览:1.6万
图书馆怎么画
时间:2019-11-06
本次我们画用书搭建起来的图书馆。首先用铅笔画出两本立起来的书。
然后继续画出一本书叠在上面,这样一个大概的框架就搭好了。
在中间的空间画出一排排整齐的书架,一本本精致的书籍,中间也画上书柜、看书的人物。
之后我们就可以开始填色了,先把外部的框架书籍填上喜欢的颜色。

Copyright 2005-2020 www.kxting.com 版权所有 |  湘ICP备2023022655号
湘ICP备2023022655号
声明: 本站所有内容均只可用于学习参考,信息与图片素材来源于互联网,如内容侵权与违规,请与本站联系,将在三个工作日内处理,联系邮箱:47085,1089@qq.com